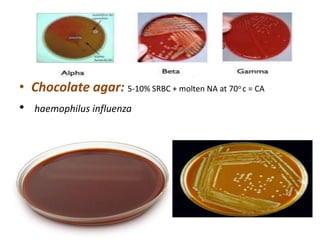
• Chocolate agar: 5-10% SRBC + molten NA at 70o c = CA
• haemophilus influenza
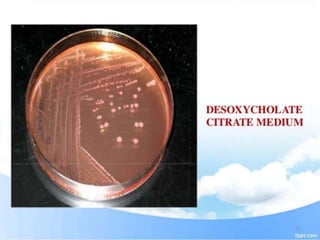
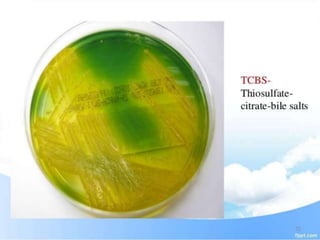
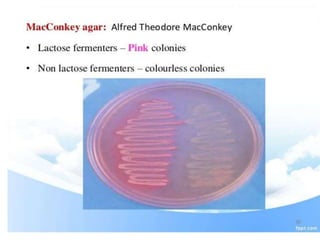

This document discusses various types of culture media used for growing bacteria. It provides details on the common constituents of culture media such as peptone, meat extract, and agar. It also describes different types of media including basal media, enriched media, differential media, and transport media. Various culture methods are outlined like streak plating, lawn culture, stab culture, and pour plating which allow isolating bacteria or assessing properties like motility.